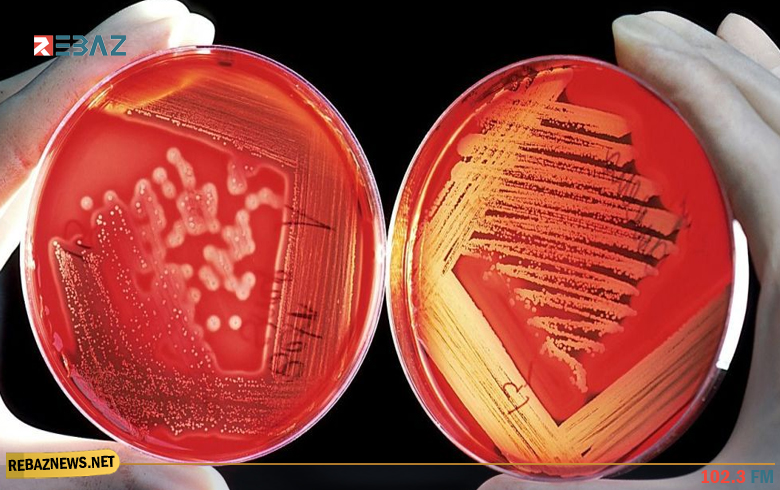

حقائق غريبة عن الدم قد لا تعرفها
تنقل خلايا الدم الأكسجين إلى جميع الخلايا من الرأس حتى أصغر أصابع القدمين، لتكمل دورتها في دقيقة، في الوقت الذي ينتج فيه الجسم كل ثانية مليوني خلية دم حمراء، تحل مكان الخلايا التي ماتت.
نعرض لكم أهم 11 حقيقة غريبة حول خلايا الدم، عددها ورحلتها وفصائلها وميزاتها التطويرية.
1- 26 مليار خلية دم حمراء: تعتبر خلايا الدم هي الأكثر وفرة في الجسم، ويصل عددها تقريبا لحوالي 26 مليار عند الرجال وهي أقل بقليل لدى النساء، ويوجد حوالي 90 في المئة من خلايا الجسم في الدم.
2- رحلة خلية الدم: تقوم كل خلية دم حمراء بـ150 ألف دورة في جسم الإنسان، كل 3 أو 4 أشهر من عمر الإنسان، من خلال الأوردة والشرايين بسرعة تصل لحوالي 2 كيلومترا في الساعة.
3- أكثر من 30 فصيلة دم: الأربعة المعروفة هي A وB وAB وO، ولكن هناك الكثير غيرها، فبحسب الطبيب روبرت فلاور من جامعة سيدني، يوجد 34 نظاما بها أكثر من 300 نوع معروف.
4- كريات الدم سبب تلون البراز باللون البني: استغناء الجسم عن خلايا الدم الحمراء القديمة لايتم بسهولة كونها تحتوي على الحديد، لذلك تستخرج بعض الخلايا الحديد وتولد إنزيماً يعرف باسم البيليروبين في نفس الوقت، والذي يصل إلى الكبد الذي يفرزه في هيئة العصارة الصفراء في الجهاز الهضمي.
5- أول عملية نقل ناجحة للدم: كانت في عام 1818 على يد طبيب النساء والتوليد البريطاني جيمس بلونديل، لامرأة عانت من نزيف دموي فور ولادتها.
6- الجسم يرفض الفصيلة الخطأ: إذا تلقى الشخص دما من فئة غير فئة دمه فإن جسمه سيحاول مهاجمة البروتينات الغريبة.
7- "AB" مستقبل عام: يمكن لجسمك تلقي أي مزيج من هذين البروتينين في عملية نقل الدم.
8- "O" معط عام: لا يحتوي الدم من الفصيلة O على أي من مولدات الضد التي يمكن أن تؤدي إلى رفض الجسم للدم، وهذه الفصيلة تخزن بشكل دائم في المستشفيات وسيارات الإسعاف.
9- "O" أقل المصابين بتجلط الأوردة العميقة: يواجه أصحاب هذه الفصيلة خطرا أقل من غيرهم في احتمال الإصابة بها.
10- بروتين يتحكم بنجاح أو فشل الحمل: يتم وريث ونقل ما يسمى بروتين "عامل Rh" من خلال الجينات، فإذا كان لديك هذا البروتين، فأنت Rh إيجابي. إذا لم يكن لديك، فأنت Rh سالب.
حيث تجري الحوامل تحاليل لمعرفة ما إذا كان لديهن سالب Rh، فإذا كان الطفل Rh موجب وتعرضت الأم لدم الطفل خلال عملية الولادة، يمكن أن يحدث تفاعل مناعي لدى الأم ينتج أجساما مضادة قد تؤدي إلى إجهاض الحمل التالي لأنها (الأجسام المضادة) تبقى في الجسم.
11- خلايا بمميزات تطورية: فبعض الخلايا أكثر مقاومة من غيرها لبعض الأمراض، فمثلا إذا كان لديك دم "نظام مستضد دافي" فأنت أكثر مقاومة للملاريا.